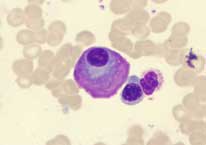

May 02, 2023
From Product Launches to Fund Raising: The Power of Events for Business Success
Events play a crucial role in the growth and success of any business. They provide a platform for businesses to interact with their clients, build relationships with pote...
Read More

May 02, 2023
Maximizing Efficiency: Latest Developments in Construction Machinery Attachments
Construction machinery attachments have come a long way since their inception. From excavators to backhoes, bulldozers to loaders, there’s no shortage of equipment in t...
Read More

May 02, 2023
A Quick Look at the Top 4 Dump Trucks and Mining Trucks in the Market for 2023
The expanse of the mining industry, be it in any country across the world, is ever-growing. It has under its purview many allied and subsidiary industries and markets. Th...
Read More

May 02, 2023
From Medicine to Automotive, Cyclic Olefin Copolymers are Changing the Game Across Numerous End-User Industries
In recent years, cyclic olefin copolymers, a versatile material, have been used for a wide range of applications including packaging, medical devices, and optical films. ...
Read More

April 25, 2023
High Frequency Ventilators: A Revolutionary Approach to Mechanical Ventilation
Mechanical ventilation has been a life-saving treatment for seriously ill patients for many years. High frequency ventilators (HFV) are a type of mechanical ventilator th...
Read More

April 25, 2023
How Can Spring Water Reverse the Damages Done by Unhealthy Urban Lifestyle?
Mineral water, as the name suggests, is glacial or mountain water which is rich in different minerals and nutrients. Mineral water is of different types depending upon th...
Read More

April 25, 2023
How Can the Incorporation of 3D Eye Tracking Software Change the Future of Retail by Unlocking Consumer Insights?
The retail industry is highly competitive, and retailers are always looking out for new ways to improve the shopping experience for their customers. One technology that i...
Read More

April 25, 2023
The Significance of Avalanche Radar Technology in an Era of Climate Change
As global temperatures rise, the snowpack can become less stable, leading to an increased risk of avalanches. Avalanches are highly deadly natural disasters that can seri...
Read More

April 20, 2023
Why is Plasma Powder Becoming a Popular Choice among Animal Feed Manufacturers?
In recent years, continuous innovations have been carried out by several organizations to incorporate essential proteins in human nutrients as well as in animal feeds. Fo...
Read More

April 20, 2023
A Comparative Analysis of Local Anesthesia Drugs, General Anesthesia, and Sedatives
It’s hard to comprehend modern-day surgeries without anesthetics. Anesthesia can be considered as a temporary and controlled loss of sensation and numbness that is purp...
Read More